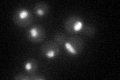
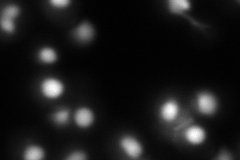
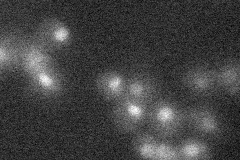
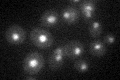

View description
Histone methyltransferase with a role in transcriptional elongation, methylates a lysine residue of histone H3; associates with the C-terminal domain of Rpo21p; histone methylation activity is regulated by phosphorylation status of Rpo21p
Localization:
Intensity:
Fold change:
Significance:
-
C’ GFP library in SD
nucleus39.21 -
N' NOP1pr-GFP in SD

nucleus48.7696 -
N' TEF2pr-mCherry in SD
nucleusN/A -
N' NATIVEpr-GFP in SD
nucleus24.5802 -
N' TEF2pr-VC and Cyto-VN in SD

#N/A0 -
C’ GFP library in SD+DTT

nucleus37.420.95No -
C’ GFP library in SD+H2O2

nucleus41.071.04No -
C’ GFP library in Starvation Media
nucleus26.730.68No -
C’ GFP library on the background of Pup2-DaMP

nucleus -
C’ GFP library on the background of CCT mutant

nucleus42.06421.07264No
